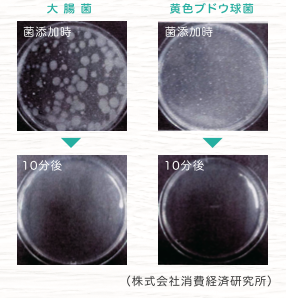

イヤなニオイを元から分解!
イヤな臭いを香りで誤魔化さず、臭いの元から分解します。
NASAも認めた、高い安全性が保証された原料のみを使用!
「光触媒」で除菌・抗菌が続く!
イヤなニオイを香りで誤魔化さず、元から分解!
ニオイの元を分解する優れた性能
「安心除菌・消臭」は塩素材よりも優れた除菌力を持ち、ほとんどの最近・ウィルス・カビなどに対して効果的、かつ安全に除菌(※)することが出来ます。
(※)全ての菌・ウィルスを除去できるわけではありません。
また、従来の「多孔質の活性炭で悪臭を閉じ込めるもの」や「芳香で悪臭を誤魔化す消臭剤」や「悪臭の分子を包み込む」などとは基本的に異なり、科学的に分解して悪臭でない物質に転換することで消臭しています。また、バクテリアやウィルスを強力に酸化させて除菌します。

NASAも認めた、高い安全性が保証された原料のみを使用!
人にも動物にも安心してお使い頂けます。
「安心除菌・消臭」に原料として使用されている「亜塩素酸ナトリウム」は、安全な水成二酸化塩素を原料としており、厚生労働省、NASAなどから様々な公的認定を受けた極めて安全性の高い原料です。
NASAではかつて「スペースシャトル内及び宇宙食の完全滅菌」に採用されていました。
近年話題となっている消毒剤の「次亜塩素酸ナトリウム」とは異なり、強い毒性や刺激性はありません。
無色・無臭で、安全な水成二酸化塩素を元に特殊加工により効果を持続させながら、塩素臭を無臭化した除菌・消臭剤として広く利用されています。
発がん性物質などの有害物質を発生させることもないため、手荒れの心配もありません。使用後も完全に分解され、環境への優しさに配慮しています。


「光触媒」で、除菌・抗菌が続く
光触媒効果を活用!
近年話題になっていた光触媒は、太陽や蛍光灯に含まれる紫外線を吸収して化学反応を起こす触媒の総称です。
酸化チタンに紫外線があたることで強力な酸化力を持つようになり、その酸化力を利用し表面接触する物質を分解する作用を光触媒と呼びます。
配合されているトリニティーによる光触媒効果で、使用後も除菌・抗菌が長持ちします。

安心除菌・消臭 500ml(ナチュラルタイプ) 2,400円(税別)
安心除菌・消臭 500ml(クールルタイプ) 2,400円(税別)
※ご使用上の注意
保管は直射日光を避け、ボトルに移し替えて使用する際は、必ず「遮光ボトル」をご使用ください。
直射日光に当てたまま保管すると品質が変わる場合があり、塗布した際に生地などが色落ちする恐れがあります。
ご注文はこちらから